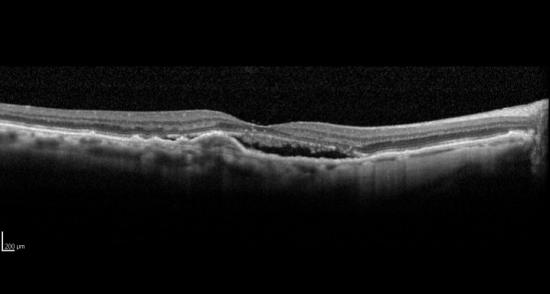
Ensayo clínico para pacientes DMAE húmeda sin respuesta óptima

Ensayo clínico en fase IV para evaluar la eficacia de aflibercept en pacientes con degeneración macular asociada a la edad (DMAE) neovascular, sin respuesta óptima a repetidas inyecciones mensuales intravitreas de anti VEGF-A. MACBETH.
Están reclutando participantes.
Web Relacionada